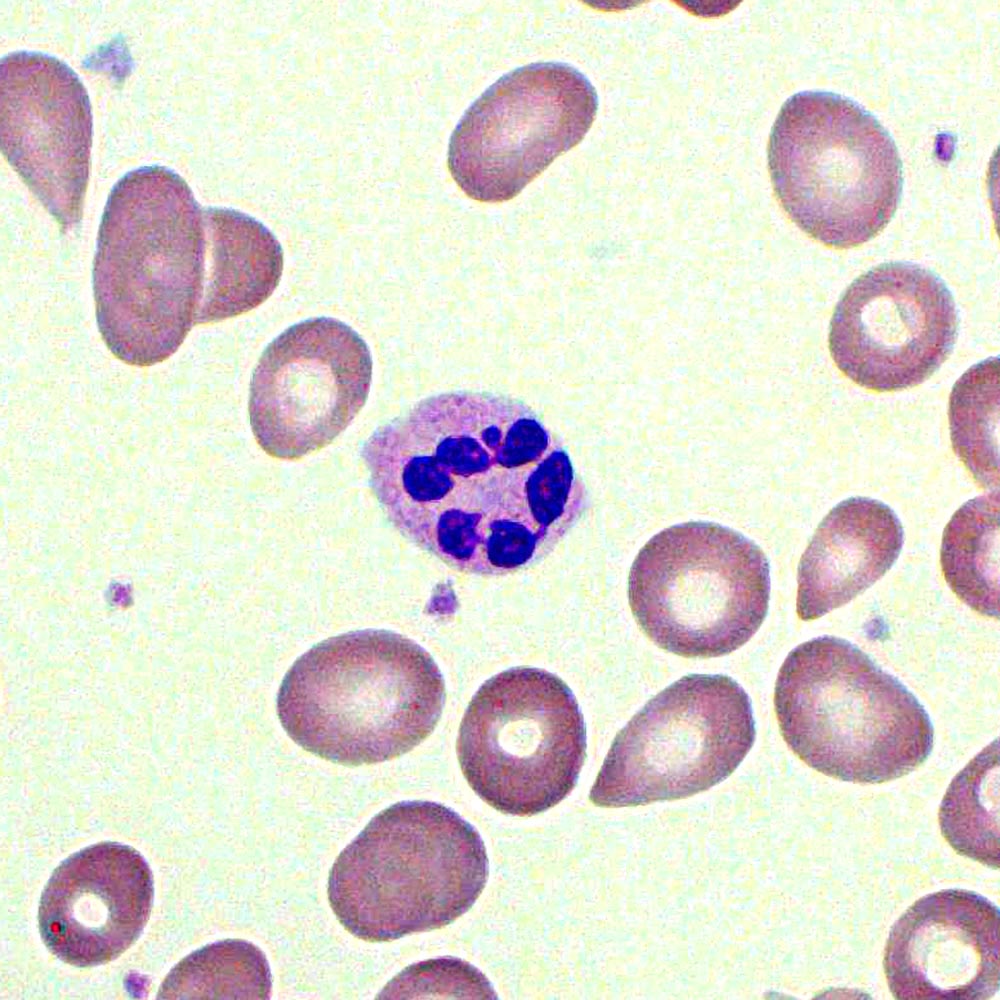
Image for question 393

Enter your email to get your 85% OFF code and unlock the full USMLE question bank on the app.
A 22-year-old man presents with lower limb weakness for the past 2 days. The patient says that the weakness started in both his feet, manifesting as difficulty walking, but it has progressed to where he cannot move his legs completely and has become bedbound. He also has experienced a recent history of numbness and tingling sensations in both his feet. He denies any recent history of fever, backache, urinary or bowel incontinence, trauma, shortness of breath, or diplopia. His past medical history is remarkable for a viral flu-like illness 2 weeks ago. The patient is afebrile, and his vital signs are within normal limits. On physical examination, muscle strength in both lower limbs is 1/5. The muscle strength in the upper limbs is ⅘ bilaterally. Sensation to pinprick is decreased in both lower limbs in a stocking distribution. The sensation is intact in the upper limbs bilaterally. Knee and ankle reflexes are absent bilaterally. The laboratory findings are significant for the following: Hemoglobin 14.2 g/dL White blood cell count 8,250/mm3 Platelet count 258,000/mm3 BUN 14 mg/dL Creatinine 0.9 mg/dL Serum sodium 144 mEq/L Serum potassium 3.9 mEq/L Which of the following tests would most likely confirm the diagnosis in this patient?
A 62-year-old man comes to the physician for decreased exercise tolerance. Over the past four months, he has noticed progressively worsening shortness of breath while walking his dog. He also becomes short of breath when lying in bed at night. His temperature is 36.4°C (97.5°F), pulse is 82/min, respirations are 19/min, and blood pressure is 155/53 mm Hg. Cardiac examination shows a high-pitch, decrescendo murmur that occurs immediately after S2 and is heard best along the left sternal border. There is an S3 gallop. Carotid pulses are strong. Which of the following is the most likely diagnosis?
A 65-year-old man presented to the hospital with a history of repeated falls, postural dizziness, progressive fatigue, generalized weakness, and a 13.6 kg (30 lb) weight loss over a duration of 6 months. He is a vegetarian. His family members complain of significant behavioral changes over the past year. The patient denies smoking, alcohol consumption, or illicit drug use. There is no significant family history of any illness. Initial examination reveals a pale, thin built man. He is irritable, paranoid, delusional, but denies any hallucinations. The blood pressure is 100/60 mm Hg, heart rate is 92/min, respiratory rate is 16/min, and the temperature is 36.1℃ (97℉). He has an unstable, wide-based ataxic gait. The anti-intrinsic factor antibodies test is positive. The laboratory test results are as follows: Hb 6.1gm/dL MCV 99 fL Platelets 900,000/mm3 Total WBC count 3,000/mm3 Reticulocyte 0.8% The peripheral blood smear is shown in the image below. What is the most likely cause of his condition?
A 38-year-old female presents to the emergency room with fevers, fatigue, and anorexia for over a month. Past medical history includes mild mitral valve prolapse. She underwent an uncomplicated tooth extraction approximately 6 weeks ago. Her vital signs include a temperature of 100.8 F, pulse of 83, blood pressure of 110/77, and SpO2 of 97% on room air. On exam, you note a grade III/VI holosystolic murmur at the apex radiating to the axilla as well as several red, painful nodules on her fingers. Which of the following is the next best course of action?
A 45-year-old woman comes to the physician for a 3-week history of intermittent episodes of dizziness. The episodes last for hours at a time and are characterized by the sensation that the room is spinning. The patient also reports that she has started using her cell phone with her left ear because she hears better on that side. She has experienced intermittent ringing and fullness in her right ear. She has no history of serious medical conditions. She does not smoke or drink alcohol. She takes no medications. Her temperature is 37.1°C (98.8°F) pulse is 76/min respirations are 18/min, and blood pressure is 130/76 mm Hg. Cardiopulmonary examination shows no abnormalities. There is horizontal nystagmus to the right. Motor strength is 5/5 in all extremities, and sensory examination shows no abnormalities. Finger-to-nose and heel-to-shin testing are normal bilaterally. Weber test shows lateralization to the left ear. The Rinne test is positive bilaterally. Which of the following is the most likely cause of this patient's symptoms?
A 21-year-old African American woman presents with difficulty breathing, chest pain, and a non-productive cough. She says she took some ibuprofen earlier but it did not improve her pain. Past medical history is significant for sickle cell disease. Medications include hydroxyurea, iron, vitamin B12, and an oral contraceptive pill. She says she received a blood transfusion 6 months ago to reduce her Hgb S below 30%. Her vital signs include: temperature 38.2°C (100.7°F), blood pressure 112/71 mm Hg, pulse 105/min, oxygen saturation 91% on room air. A chest radiograph is performed and is shown in the exhibit. Which of the following is best initial step in the management of this patient's condition?

A 63-year-old woman presents to your outpatient clinic complaining of headaches, blurred vision, and fatigue. She has a blood pressure of 171/91 mm Hg and heart rate of 84/min. Physical examination is unremarkable. Her lab results include K+ of 3.1mEq/L and a serum pH of 7.51. Of the following, which is the most likely diagnosis for this patient?
A 26-year-old man presents with a 2-day history of worsening right lower leg pain. He states that he believes his right leg is swollen when compared to his left leg. Past medical history is significant for generalized anxiety disorder, managed effectively with psychotherapy. He smokes a pack of cigarettes daily but denies alcohol and illicit drug use. His father died of a pulmonary embolism at the age of 43. His vital signs include: temperature 36.7°C (98.0°F), blood pressure 126/74 mm Hg, heart rate 74/min, respiratory rate 14/min. On physical examination, the right lower leg is warmer than the left, and dorsiflexion of the right foot produces pain. Which of the following conditions is most likely responsible for this patient’s presentation?
A 70-year-old man presents with a complaint of progressive dyspnea on minimal exertion. The patient reports being quite active and able to climb 3 flights of stairs in his building 10 years ago, whereas now he feels extremely winded when climbing a single flight. At first, he attributed this to old age but has more recently begun noticing that he feels similarly short of breath when lying down. He denies any recent fevers, cough, chest pain, nausea, vomiting, or diarrhea. He denies any past medical history except for two hospitalizations over the past 10 years for "the shakes." Family history is negative for any heart conditions. Social history is significant for a 10 pack-year smoking history. He currently drinks "a few" drinks per night. On exam, his vitals are: BP 120/80, HR 85, RR 14, and SpO2 97%. He is a mildly obese man who appears his stated age. Physical exam is significant for a normal heart exam with a few crackles heard at the bases of both lungs. Abdominal exam is significant for an obese abdomen and a liver edge palpated 2-3 cm below the costal margin. He has 2+ edema present in both lower extremities. Lab results reveal a metabolic panel significant for a sodium of 130 mEq/L but otherwise normal. Complete blood count, liver function tests, and coagulation studies are normal as well. An EKG reveals signs of left ventricular enlargement with a first degree AV block. A cardiac catheterization report from 5 years ago reveals a moderately enlarged heart but patent coronary arteries. Which of the following is the most likely cause of this individual's symptoms?
A 61-year-old man comes to the physician because of a 3-month history of fatigue and progressively worsening shortness of breath that is worse when lying down. Recently, he started using two pillows to avoid waking up short of breath at night. Examination shows a heart murmur. A graph with the results of cardiac catheterization is shown. Given this patient's valvular condition, which of the following murmurs is most likely to be heard on cardiac auscultation?

Hypertension diagnosis and management
Practice Questions
Stable coronary artery disease
Practice Questions
Peripheral arterial disease
Practice Questions
Aortic diseases
Practice Questions
Valvular heart disease
Practice Questions
Pericardial diseases
Practice Questions
Adult congenital heart disease
Practice Questions
Cardiac tumors
Practice Questions
Cardiac manifestations of systemic diseases
Practice Questions
Pre-operative cardiac risk assessment
Practice Questions
Cardiac imaging modalities
Practice Questions
Preventive cardiology
Practice Questions
Cardiac rehabilitation
Practice Questions
Get full access to all questions, explanations, and performance tracking.
Scan to download app